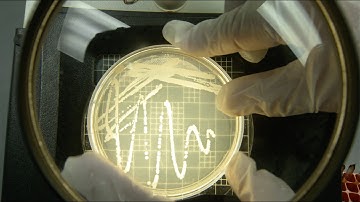
We Are Planetary Protection

⬇ DOWNLOAD NOW
Kalau muncul iklan pop-up, tutup lalu klik tombol kembali
Download lagu What Is A Clean Room And How Does It Help Planetary Protection? - Astronomy Made Simple secara gratis hanya untuk keperluan promosi. Dukung artis favorit kamu dengan membeli musik original di iTunes atau platform resmi lainnya.
 Planetary Protection: Preventing contamination
Planetary Protection: Preventing contamination
 Microbiome complexity in a NASA cleanroom facility affects planetary protection
Microbiome complexity in a NASA cleanroom facility affects planetary protection
 How Does Planetary Protection Prevent Forward Contamination? - All About Astronauts
How Does Planetary Protection Prevent Forward Contamination? - All About Astronauts
 What Is Planetary Protection In Space? - All About Astronauts
What Is Planetary Protection In Space? - All About Astronauts
 How Does Planetary Protection Prevent Space Contamination? - All About Astronauts
How Does Planetary Protection Prevent Space Contamination? - All About Astronauts
We Are Planetary Protection
We Are Planetary Protection
 What Is Planetary Protection In Space Exploration? - All About Astronauts
What Is Planetary Protection In Space Exploration? - All About Astronauts
 What Is Planetary Protection For Ocean Worlds? - All About Astronauts
What Is Planetary Protection For Ocean Worlds? - All About Astronauts